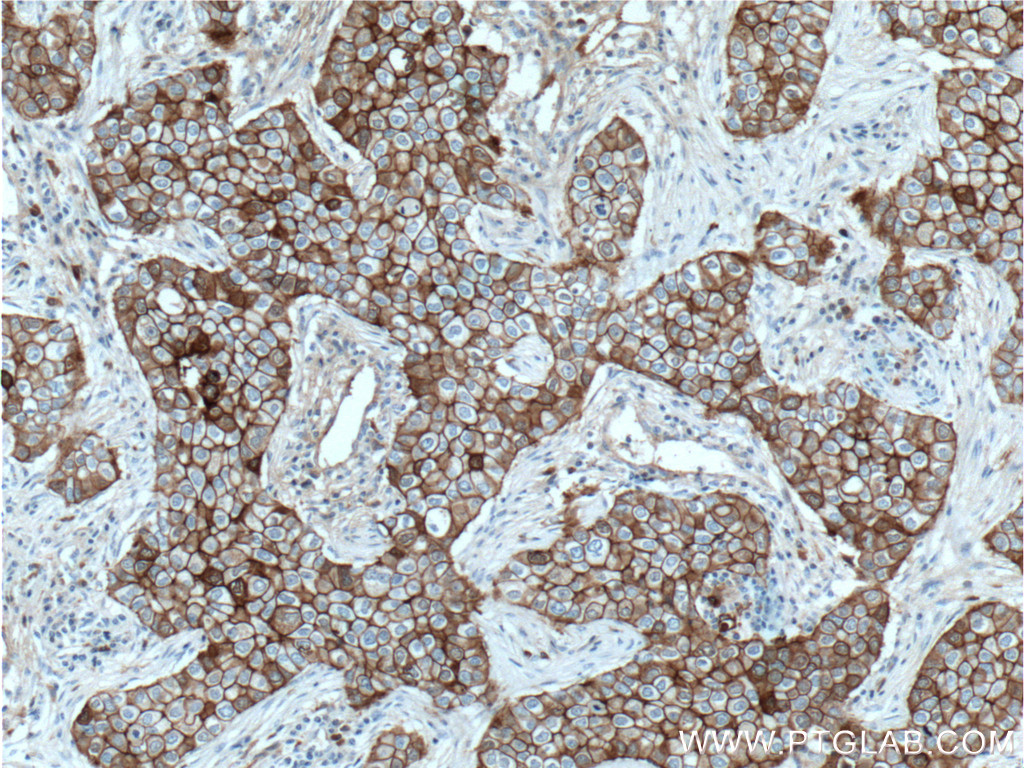

PC-3, MKN-45, SGC-7901 cells were subjected to SDS PAGE followed by western blot with 60335-1-Ig (E-cadherin Antibody) at dilution of 1:4000 incubated at room temperature for 1.5 hours.
Various lysates were subjected to SDS PAGE followed by western blot with 66219-1-Ig (N-cadherin antibody) at dilution of 1:20000 incubated at room temperature for 1.5 hours.
Various lysates were subjected to SDS PAGE followed by western blot with 80232-1-RR (Vimentin antibody) at dilution of 1:50000 incubated at room temperature for 1.5 hours.
Various lysates were subjected to SDS PAGE followed by western blot with 13099-1-AP (SNAI1 antibody) at dilution of 1:1500 incubated at room temperature for 1.5 hours.
Western blot analysis of MMP2 in various cell lines using Proteintech antibody 66366-1-Ig (MMP2 Antibody) at dilution of 1:3000 incubated at room temperature for 1.5 hours.
Various lysates were subjected to SDS PAGE followed by western blot with 66042-1-Ig (Fibronectin antibody) at dilution of 1:10000 incubated at room temperature for 1.5 hours.
Various lysates were subjected to SDS PAGE followed by western blot with 66452-1-Ig (ZO-1 antibody) at dilution of 1:3000 incubated at room temperature for 1.5 hours.
Various lysates were subjected to SDS PAGE followed by western blot with 25465-1-AP (TWIST1-specific antibody) at dilution of 1:2000 incubated at room temperature for 1.5 hours.
Various lysates were subjected to SDS PAGE followed by western blot with 10375-2-AP (MMP9 (N-terminal) antibody) at dilution of 1:1500 incubated at room temperature for 1.5 hours.
Various lysates were subjected to SDS PAGE followed by western blot with 28674-1-AP (Claudin 1 antibody) at dilution of 1:3000 incubated at room temperature for 1.5 hours.
IP Result of anti-SNAI1 (IP:13099-1-AP, 4ug; Detection:13099-1-AP 1:600) with MCF-7 cells lysate 1040ug.
IP Result of anti-Fibronectin (IP:66042-1-Ig, 5ug; Detection:66042-1-Ig 1:500) with human plasma lysate 4000ug.
IP Result of anti-TWIST1-specific (IP:25465-1-AP, 4ug; Detection:25465-1-AP 1:500) with MDA-MB-453s cells lysate 920ug.
Immunohistochemical analysis of paraffin-embedded human breast cancer tissue slide using 60335-1-Ig (E-cadherin antibody) at dilution of 1:2000 (under 10x lens. Heat mediated antigen retrieval with Tris-EDTA buffer (pH 9.0).
Immunohistochemical analysis of paraffin-embedded human malignant melanoma tissue slide using 66219-1-Ig (N-cadherin antibody) at dilution of 1:5000 (under 10x lens). Heat mediated antigen retrieval with Tris-EDTA buffer (pH 9.0).
Immunohistochemical analysis of paraffin-embedded human breast cancer tissue slide using 80232-1-RR (Vimentin antibody) at dilution of 1:2500 (under 10x lens). Heat mediated antigen retrieval with Tris-EDTA buffer (pH 9.0).
Immunohistochemical analysis of paraffin-embedded human stomach cancer tissue slide using 13099-1-AP (SNAI1 antibody) at dilution of 1:200 (under 10x lens). Heat mediated antigen retrieval with Tris-EDTA buffer (pH 9.0).
Immunohistochemical analysis of paraffin-embedded human breast cancer tissue slide using 66366-1-Ig (MMP2 antibody) at dilution of 1:300 (under 10x lens. Heat mediated antigen retrieval with Tris-EDTA buffer (pH 9.0).
Immunohistochemical analysis of paraffin-embedded human colon cancer tissue slide using 66042-1-Ig (Fibronectin antibody) at dilution of 1:600 (under 40x lens. Heat mediated antigen retrieval with Tris-EDTA buffer (pH 9.0).
Immunohistochemical analysis of paraffin-embedded human pancreas cancer tissue slide using 66452-1-Ig (ZO-1 antibody) at dilution of 1:400 (under 10x lens. Heat mediated antigen retrieval with Tris-EDTA buffer (pH 9.0).
Immunohistochemical analysis of paraffin-embedded human pancreas cancer tissue slide using 25465-1-AP (TWIST1-specific antibody) at dilution of 1:200 (under 40x lens. Heat mediated antigen retrieval with Tris-EDTA buffer (pH 9.0).
Immunohistochemical analysis of paraffin-embedded human cervical cancer tissue slide using 10375-2-AP (MMP9 (N-terminal) antibody) at dilution of 1:200 (under 10x lens). Heat mediated antigen retrieval with Tris-EDTA buffer (pH 9.0).
Immunohistochemical analysis of paraffin-embedded human colon cancer tissue slide using 28674-1-AP (Claudin 1 antibody) at dilution of 1:1000 (under 10x lens). Heat mediated antigen retrieval with Tris-EDTA buffer (pH 9.0).
Immunofluorescent analysis of (4% PFA) fixed human breast cancer tissue using E-cadherin antibody (60335-1-Ig, Clone: 6B11F11 ) at dilution of 1:400 and CoraLite®488-Conjugated AffiniPure Goat Anti-Mouse IgG(H+L).
Immunofluorescent analysis of (4% PFA) fixed mouse heart tissue using 66219-1-Ig (N-cadherin antibody) at dilution of 1:100 and CoraLite594-Conjugated AffiniPure Goat Anti-Mouse IgG(H+L). The section was co-stained with 11313-2-AP (alpha Actinin) in green.
Immunofluorescent analysis of (-20°C Ethanol) fixed HepG2 cells using Vimentin antibody (80232-1-RR, Clone: 6K21 ) at dilution of 1:400 and CoraLite®488-Conjugated AffiniPure Goat Anti-Rabbit IgG(H+L).
Immunofluorescent analysis of (4% PFA) fixed human colon cancer tissue using Fibronectin antibody (66042-1-Ig, Clone: 1G10F9 ) at dilution of 1:400 and CoraLite®488-Conjugated AffiniPure Goat Anti-Mouse IgG(H+L).
Immunofluorescent analysis of (4% PFA) fixed MCF-7 cells using ZO-1 antibody (66452-1-Ig, Clone: 1G4A1 ) at dilution of 1:1500 and CoraLite®488-Conjugated AffiniPure Goat Anti-Mouse IgG(H+L), Alpha Tubulin antibody (11224-1-AP, red).
Immunofluorescent analysis of (4% PFA) fixed HepG2 cells using 25465-1-AP (TWIST1-specific antibody) at dilution of 1:50 and Alexa Fluor 488-Conjugated AffiniPure Goat Anti-Rabbit IgG(H+L).
Immunofluorescent analysis of (-20°C Ethanol) fixed HepG2 cells using MMP9 (N-terminal) antibody (10375-2-AP) at dilution of 1:400 and CoraLite®488-Conjugated AffiniPure Goat Anti-Rabbit IgG(H+L), CL594-Phalloidin (red).
Immunofluorescent analysis of (-20°C Methanol) fixed HaCaT cells using Claudin 1 antibody (28674-1-AP) at dilution of 1:200 and CoraLite®488-Conjugated Goat Anti-Rabbit IgG(H+L) (SA00013-2).